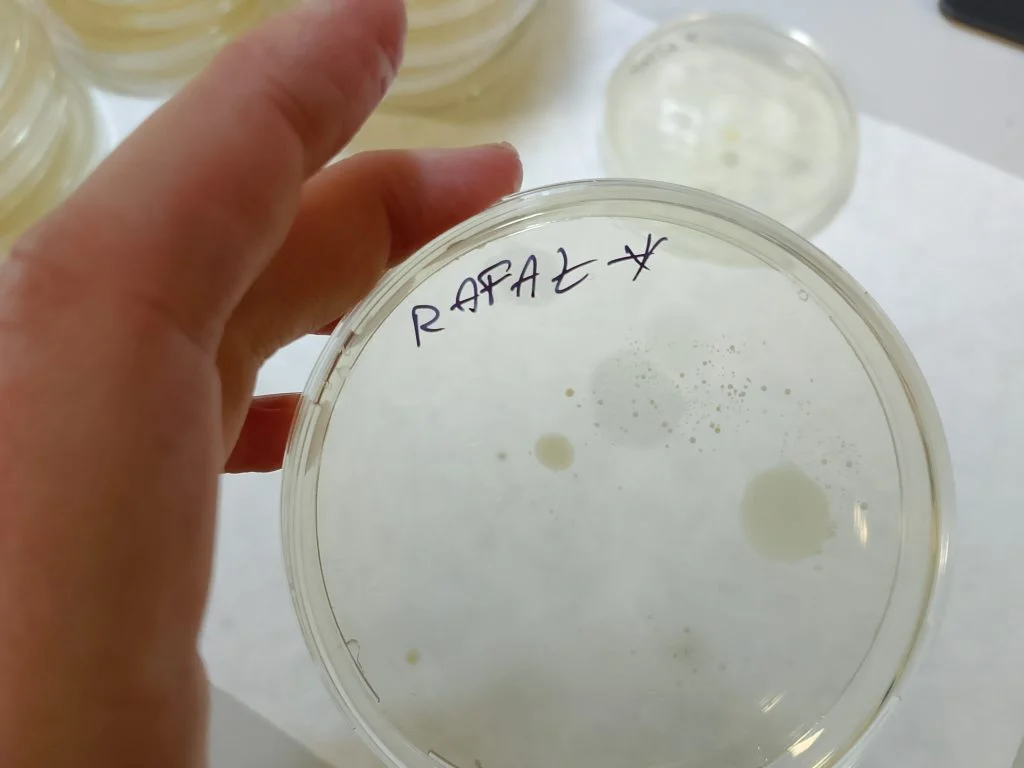
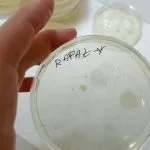

Dolnośląski Festiwal Nauki 2026
Szanowni Państwo,
zapraszamy do udziału – w roli wykładowców i prowadzących warsztaty – w Dolnośląskim Festiwalu Nauki.
Edycja wrocławska odbywa się w dniach 12-18 września (od soboty do następnego piątku).
W sobotę 12 września odbędzie się Miasteczko Naukowe na Placu Solnym. W zeszłym roku udało nam się zaistnieć również na scenie festiwalowej, w tym roku mamy nadzieję na przynajmniej tyle samo.
W piątek 18 września planowany jest panel imprez „wieczornych” jako IV Noc Naukowców – zapraszamy również do rozważenia tego terminu, będzie to szansa na dotarcie do grupy osób które nie maja czasu na przyjście „w godzinach pracy”.
Hasłem tegorocznego Festiwalu jest „Poznaj, polub, pamiętaj” – dosyć oczywista kontra do „zakuj, zdaj, zapomnij” ale też po prostu dobry opis tego, jak uczymy się i uczymy kogoś otaczającego nas świata.
Planując wykłady i warsztaty można je spersonalizować pod konkretną grupę wiekową (liceum, wczesna podstawówka, itd.) lub zaplanować w trybie otwartym.
Bardzo prosimy o zgłaszanie chęci udziału do koordynatora wydziałowego (Joanna Grzyb, joanna.grzyb@uwr.edu.pl, https://www.facebook.com/joanna.m.grzyb), do dnia 1 kwietnia (albo „do Wielkanocy”) lub do samodzielnego wypełnienia formularza na stronie festiwalu i przesłania do dr Grzyb wygenerowanego przez system zgłoszenia.
Zapraszamy również do obejrzenia fotorelacji z poprzedniej edycji: